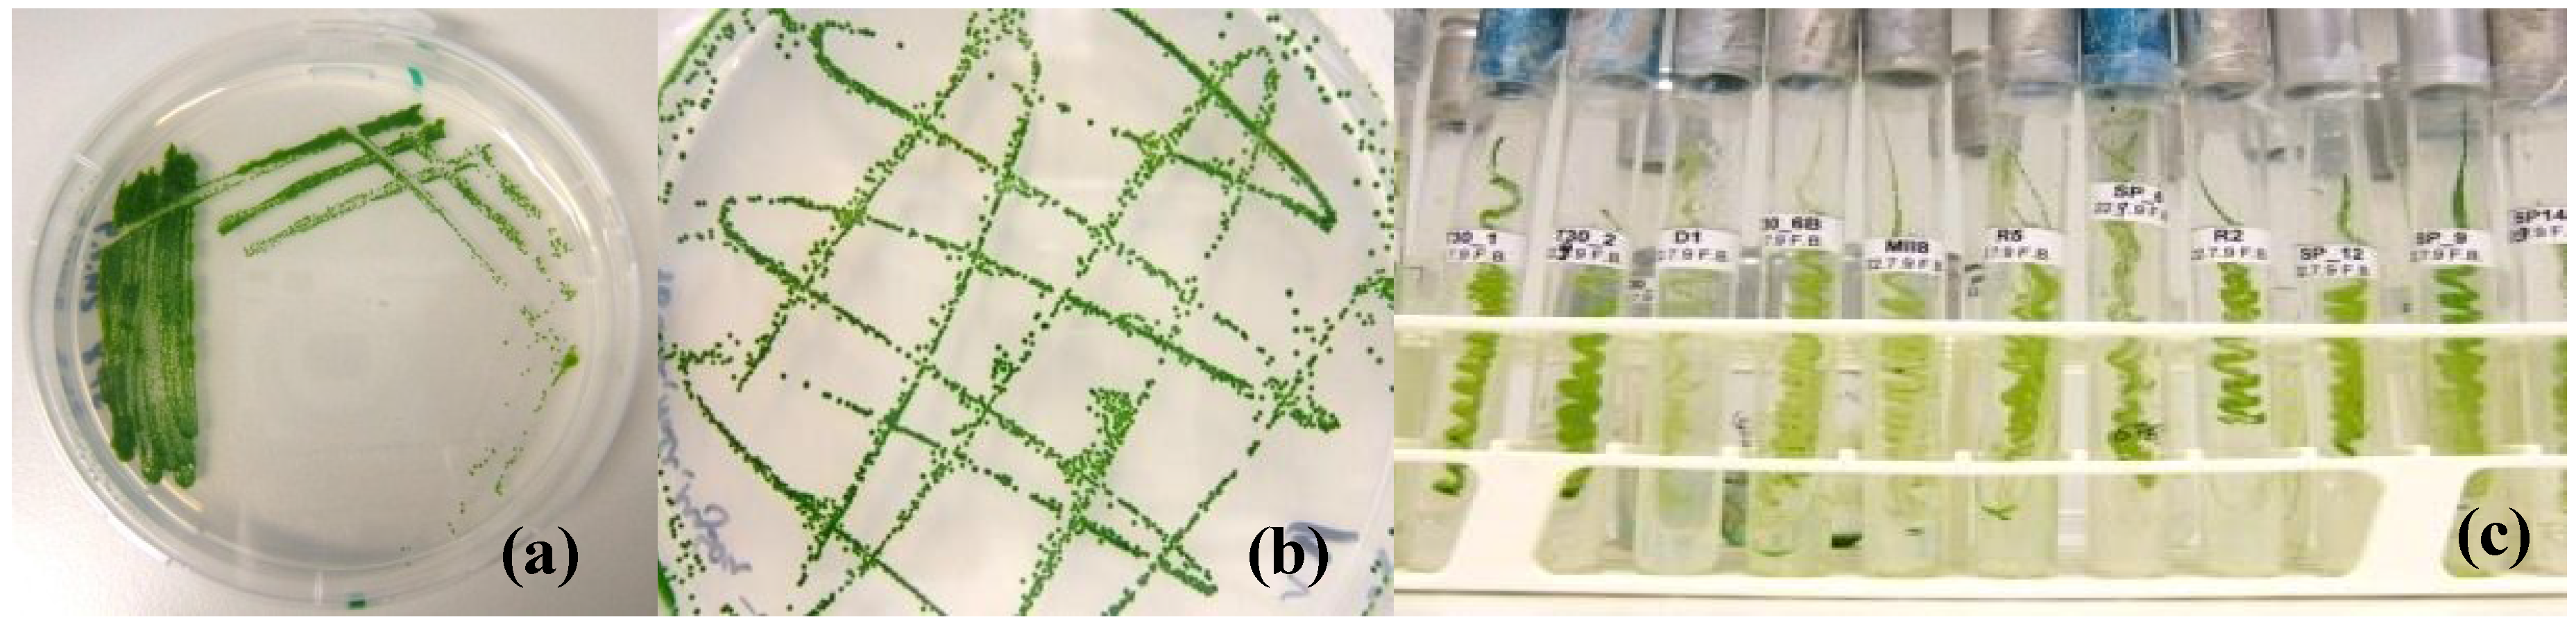

Isolation and Characterization of New Temperature Tolerant Microalgal Strains for Biomass Production
Abstract
:1. Introduction
2. Results and Discussion
2.1. Sampling and Enrichment

2.2. Temperature Tolerance and Growth Kinetics

| Isolate | µ day−1 | Maximal Temperature [°C] |
|---|---|---|
| T306A | 1.163 | 45 |
| Sp1 | 1.101 | 40 |
| CS | 0.943 | 45 |
| T301 | 0.890 | 45 |
| I5 | 0.832 | 45 |
| Sp12 | 0.827 | 45 |
| Sp13 | 0.766 | 45 |
| Sp14 | 0.683 | 45 |
| T308 | 0.667 | 40 |
| Sp9 | 0.646 | 45 |
| GDK | 0.625 | 40 |
| T302 | 0.585 | 45 |
| T306B | 0.564 | 45 |
| T307 | 0.525 | 40 |
| I4 | 0.469 | 45 |
| Sp6 | 0.455 | 40 |
| R6 | 0.423 | 45 |
| R4 | 0.382 | 40 |
| Ssp | 0.371 | 40 |
| R3 | 0.328 | 45 |
| I1 | 0.144 | 35 |
| I3 | 0.105 | 40 |
| Isolate | µ day−1 (22 ± 1 °C) | µ day−1 (45 °C) |
|---|---|---|
| Sp13 | 0.766 | 0.53 |
| CS | 0.943 | 0.42 |
| I4 | 0.469 | 0.4 |
| I5 | 0.832 | 0.39 |
| Sp14 | 0.683 | 0.37 |
2.3. Establishment of Unialgal Cultures
2.4. Molecular Identification

3. Experimental Section
3.1. Sample Collection and Incubation
3.2. Temperature Tolerance Test
3.3. Establishment of Pure Cultures
3.4. Growth Kinetics
3.5. Molecular Identification
| Primer | Sequence | Reference |
|---|---|---|
| EukA | 5'-AAC CTG GTT GAT CCT GCC AGT-3' | [26], no polylinker |
| EukB | 5'-TGA TCC TTC TGC AGG TTC ACC TAC-3' | |
| 1055f | 5'-GGT GGT GCA TGG CCG TTC TT-3' | [27] |
| 1055r | 5'-ACG GCC ATG CAC CAC CAC CCA T-3' |
4. Conclusions
Supplementary Materials
Acknowledgments
Author Contributions
Conflicts of Interest
References
- Mata, T.M.; Martins, A.A.; Caetano, N.S. Microalgae for biodiesel production and other applications: A review. Renew. Sustain. Energy Rev. 2010, 14, 217–232. [Google Scholar] [CrossRef]
- Chisti, Y. Biodiesel from microalgae. Biotechnol. Adv. 2007, 25, 294–306. [Google Scholar] [CrossRef] [PubMed]
- De Clerck, O.; Guiry, M.D.; Leliaert, F.; Samyn, Y.; Verbruggen, H. Algal taxonomy: A road to nowhere? J. Phycol. 2013, 49, 215–225. [Google Scholar] [CrossRef]
- Guiry, M.D. How many species of algae are there? J. Phycol. 2012, 48, 1057–1063. [Google Scholar] [CrossRef]
- Spolaore, P.; Joannis-Cassan, C.; Duran, E.; Isambert, A. Commercial applications of microalgae. J. Biosci. Bioeng. 2006, 101, 87–96. [Google Scholar] [CrossRef] [PubMed]
- Ras, M.; Steyer, J.P.; Bernard, O. Temperature effect on microalgae: A crucial factor for outdoor production. Rev. Environ. Sci. Bio-Technol. 2013, 12, 153–164. [Google Scholar] [CrossRef]
- William, K.W.; Morris, I. Temperature adaption in Phaeodactylum tricornutum Bohlin: Photosynthetic rate compensation and capacity. J. Exp. Mar. Biol. Ecol. 1982, 58, 135–150. [Google Scholar] [CrossRef]
- Hanagata, N.; Takeuchi, T.; Fukuju, Y.; Barnes, D.J.; Karube, I. Tolerance of microalgae to high CO2 and high-temperature. Phytochemistry 1992, 31, 3345–3348. [Google Scholar] [CrossRef]
- Converti, A.; Casazza, A.A.; Ortiz, E.Y.; Perego, P.; del Borghi, M. Effect of temperature and nitrogen concentration on the growth and lipid content of Nannochloropsis oculata and Chlorella vulgaris for biodiesel production. Chem. Eng. Process. 2009, 48, 1146–1151. [Google Scholar] [CrossRef]
- Li, X.; Hu, H.Y.; Zhang, Y.P. Growth and lipid accumulation properties of a freshwater microalga Scenedesmus sp. under different cultivation temperature. Bioresour. Technol. 2011, 102, 3098–3102. [Google Scholar] [CrossRef] [PubMed]
- Butterwick, C.; Heaney, S.I.; Talling, J.F. Diversity in the influence of temperature on the growth rates of freshwater algae, and its ecological relevance. Freshw. Biol. 2005, 50, 291–300. [Google Scholar] [CrossRef]
- Salvucci, M.E.; Crafts-Brandner, S.J. Relationship between the heat tolerance of photosynthesis and the thermal stability of Rubisco activase in plants from contrasting thermal environments. Plant Physiol. 2004, 134, 1460–1470. [Google Scholar] [CrossRef] [PubMed]
- Hase, R.; Oikawa, H.; Sasao, C.; Morita, M.; Watanabe, Y. Photosynthetic production of microalgal biomass in a raceway system under greenhouse conditions in Sendai city. J. Biosci. Bioeng. 2000, 89, 157–163. [Google Scholar] [CrossRef] [PubMed]
- Bechet, Q.; Munoz, R.; Shilton, A.; Guieysse, B. Outdoor cultivation of temperature-tolerant Chlorella sorokiniana in a column photobioreactor under low power-input. Biotechnol. Bioeng. 2013, 110, 118–126. [Google Scholar] [CrossRef] [PubMed]
- Ong, S.C.; Kao, C.Y.; Chiu, S.Y.; Tsai, M.T.; Lin, C.S. Characterization of the thermal-tolerant mutants of Chlorella sp. with high growth rate and application in outdoor photobioreactor cultivation. Bioresour. Technol. 2010, 101, 2880–2883. [Google Scholar] [CrossRef] [PubMed]
- Bechet, Q.; Shilton, A.; Fringer, O.B.; Munoz, R.; Guieysse, B. Mechanistic modeling of broth temperature in outdoor photobioreactors. Environ. Sci. Technol. 2010, 44, 2197–2203. [Google Scholar] [CrossRef] [PubMed]
- Doucha, J.; Livansky, K. Outdoor open thin-layer microalgal photobioreactor: Potential productivity. J. Appl. Phycol. 2009, 21, 111–117. [Google Scholar] [CrossRef]
- Dalrymple, O.K.; Halfhide, T.; Udom, I.; Gilles, B.; Wolan, J.; Zhang, Q.; Ergas, S. Wastewater use in algae production for generation of renewable resources: A review and preliminary results. Aquat. Biosyst. 2013, 9, 1–11. [Google Scholar] [CrossRef]
- Zuppini, A.; Andreoli, C.; Baldan, B. Heat stress: An inducer of programmed cell death in Chlorella saccharophila. Plant Cell Physiol. 2007, 48, 1000–1009. [Google Scholar] [CrossRef] [PubMed]
- Winckelmann, D.; Bleeke, F.; Bergmann, P.; Klöck, G. Growth of Cyanobacterium aponinum influenced by increasing salt concentrations and temperature. 3 Biotech 2014. [Google Scholar] [CrossRef]
- Kessler, E. Upper limits of temperature for growth in Chlorella (Chlorophyceae). Plant Syst. Evol. 1985, 151, 67–71. [Google Scholar] [CrossRef]
- Cypionka, H. Grundlagen der Mikrobiologie; Springer: Berlin, Germany, 2010. [Google Scholar]
- Vaulot, D.; Eikrem, W.; Viprey, M.; Moreau, H. The diversity of small eukaryotic phytoplankton (< or =3 microm) in marine ecosystems. FEMS Microbiol. Rev. 2008, 32, 795–820. [Google Scholar] [CrossRef]
- Leliaert, F.; Smith, D.R.; Moreau, H.; Herron, M.D.; Verbruggen, H.; Delwiche, C.F.; de Clerck, O. Phylogeny and molecular evolution of the green algae. Crit. Rev. Plant Sci. 2012, 31, 1–46. [Google Scholar] [CrossRef]
- Keeling, P.J.; Burger, G.; Durnford, D.G.; Lang, B.F.; Lee, R.W.; Pearlman, R.E.; Roger, A.J.; Gray, M.W. The tree of eukaryotes. Trends Ecol. Evol. 2005, 20, 670–676. [Google Scholar] [CrossRef] [PubMed]
- Medlin, L.; Elwood, H.J.; Stickel, S.; Sogin, M.L. The characterization of enzymatically amplified eukaryotic 16S-like rRNA-coding regions. Gene 1988, 71, 491–499. [Google Scholar] [CrossRef] [PubMed]
- Elwood, H.J.; Olsen, G.J.; Sogin, M.L. Ther small-subunit ribosomal-RNA gene-sequences from the hypotrichous ciliates Oxytricha-nova and Stylonychia-pustulata. Mol. Biol. Evol. 1985, 2, 399–410. [Google Scholar] [PubMed]
© 2014 by the authors; licensee MDPI, Basel, Switzerland. This article is an open access article distributed under the terms and conditions of the Creative Commons Attribution license (http://creativecommons.org/licenses/by/4.0/).
Share and Cite
Bleeke, F.; Rwehumbiza, V.M.; Winckelmann, D.; Klöck, G. Isolation and Characterization of New Temperature Tolerant Microalgal Strains for Biomass Production. Energies 2014, 7, 7847-7856. https://doi.org/10.3390/en7127847
Bleeke F, Rwehumbiza VM, Winckelmann D, Klöck G. Isolation and Characterization of New Temperature Tolerant Microalgal Strains for Biomass Production. Energies. 2014; 7(12):7847-7856. https://doi.org/10.3390/en7127847
Chicago/Turabian StyleBleeke, Franziska, Vincent M. Rwehumbiza, Dominik Winckelmann, and Gerd Klöck. 2014. "Isolation and Characterization of New Temperature Tolerant Microalgal Strains for Biomass Production" Energies 7, no. 12: 7847-7856. https://doi.org/10.3390/en7127847
APA StyleBleeke, F., Rwehumbiza, V. M., Winckelmann, D., & Klöck, G. (2014). Isolation and Characterization of New Temperature Tolerant Microalgal Strains for Biomass Production. Energies, 7(12), 7847-7856. https://doi.org/10.3390/en7127847
